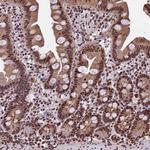
POLR3E Antibody in Immunohistochemistry (Paraffin) (IHC (P))

Search
Invitrogen
POLR3E Polyclonal Antibody
{{$productOrderCtrl.translations['antibody.pdp.commerceCard.promotion.promotions']}}
{{$productOrderCtrl.translations['antibody.pdp.commerceCard.promotion.viewpromo']}}
{{$productOrderCtrl.translations['antibody.pdp.commerceCard.promotion.promocode']}}: {{promo.promoCode}} {{promo.promoTitle}} {{promo.promoDescription}}. {{$productOrderCtrl.translations['antibody.pdp.commerceCard.promotion.learnmore']}}

Please note: We are reviewing Western blot images included in the antibody testing data in our catalog, including those provided by third parties. Unless expressly labeled or annotated as “raw-unedited”, Western blot images included in the antibody testing data in our catalog may have been edited, optimized or otherwise adjusted for presentation.
产品信息
PA5-59585
种属反应
宿主/亚型
分类
类型
抗原
偶联物
形式
浓度
规格
纯化类型
保存液
内含物
保存条件
运输条件
RRID
产品详细信息
Immunogen sequence: FVMWKFTQSR WVVRKEVATV TKLCAEDVKD FLEHMAVVRI NKGWEFILPY DGEFIKKHPD VVQRQHMLWT GIQAKLEKVY NLVKETMPKK PDAQ
Highest antigen sequence identity to the following orthologs: Mouse - 95%, Rat - 93%.
靶标信息
DNA-dependent RNA polymerase catalyzes the transcription of DNA into RNA using the four ribonucleoside triphosphates as substrates. Specific peripheric component of RNA polymerase III which synthesizes small RNAs, such as 5S rRNA and tRNAs. Essential for efficient transcription from both the type 2 VAI and type 3 U6 RNA polymerase III promoters. Plays a key role in sensing and limiting infection by intracellular bacteria and DNA viruses. Acts as nuclear and cytosolic DNA sensor involved in innate immune response. Can sense non-self dsDNA that serves as template for transcription into dsRNA. The non-self RNA polymerase III transcripts, such as Epstein-Barr virus-encoded RNAs (EBERs) induce type I interferon and NF- Kappa-B through the RIG-I pathway.
仅用于科研。不用于诊断过程。未经明确授权不得转售。
篇参考文献 (0)
生物信息学
蛋白别名: DNA-directed RNA polymerase III 80 kDa polypeptide; DNA-directed RNA polymerase III subunit RPC5; RNA polymerase III subunit C5
基因别名: KIAA1452; POLR3E
Entrez Gene ID: (Human) 55718




